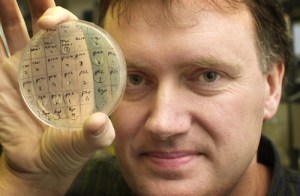
FOR SCIENCE PAGE... Professor Luke O'Neill of the Biotechnology Institute in TCD with clones of the Toll-like receptor 3 gene which is disabled by Pox viruses. Photograph: Frank Miller 5.3.03

Ireland’s dire showing in the latest round of European Research Council (ERC) advanced grants last week, suggests that basic scientific research here is not up to European, let alone world, standards.
There was 445 million euro awarded last week by the ERC in advanced grants – the gold standard in European scientific excellence these days. There were 190 new advanced research grantees across Europe.
Ireland’s return? One new advanced grant out of 190, and the one that we did get wasn’t awarded to a scientist. It went to Poul Holm, an environmental historian based at Trinity College Dublin.
It’s stunning that not one scientist based in Ireland, out of 190 awardees, received an advanced grant award. Ireland simply wasn’t mapped. It’s true to say that Ireland did receive 30 million euro in consolidator and starter grants, which is very welcome.
But, at senior level, where it really matters, Irish science got nothing. To ‘celebrate’ the awarding of the 30 million as Science Foundation Ireland (SFI) did in a press release seems delusional. It is bit like Leitrim football supporters believing a senior All Ireland title is due in the next few years, because they have a couple of promising underage players.
Many of the best scientists working in Europe are supported by advanced grants from the European Research Council (ERC) which was set up in 2007, among them several Nobel Prize winners. That’s where it’s at in Europe these days, if you are a serious, top level scientist.
“It doesn’t look good whatever way you look at it as the advanced grant is definitely seen as the Champions League of Europe,” said Professor Luke O’Neill, Trinity College Dublin, a holder of an advanced grant.
Questions must now be asked of the whole direction of science strategy here. Quite simply, there is not enough being done by Science Foundation Ireland (SFI), the main body supporting science here, and the Irish government to get Ireland-based researchers up to the level of ERC advanced grant awards.
“One point I have made repeatedly is that unless SFI supports outstanding basic research,” said Prof O’Neill, ‘”it will definitely limit out capacity to get ERC funding and that might well be what’s happened here.”
Basic failure
Ireland’s poor performance at advanced ERC level is nothing new. Since 2007, there have been just 10 advanced awardees, including the latest one, out of a total of approximately 1,800.
That’s a return of some 0.5% of the awards for the best, most innovative research in Europe over an eight year period, and calls into question the Government’s strategy of allowing industry-led research clusters to drive the research agenda in Ireland.
It means that despite the talk of world class research going on here that the reality is that Ireland is not even close to the top of the European research league table.
The lack of sufficient support for top quality basic research here means Irish science risks becoming something that is just done to suit the immediate needs of industry. Science here follows, while real breakthroughs are made elsewhere
“An ERC advanced grant has to be truly innovative in the real sense of the word – if the project works it will break new scientific ground, not a new technology,” said Prof O’Neill.
Professor Rob Kitchin, another advanced ERC grantee, at Maynooth University, said that the fact that Ireland spends less as a percentage of its GDP on research than many other countries, while what we do spend is pushed towards applied rather than basic research, means that it is not surprising that we are not doing well at advanced ERC grant level.
“My personal view is that if Ireland wants to do really well on ERCs and university rankings then it should invest more heavily in humanities and social sciences where we perform better in many rankings than we do in a lot of sciences – and it would be easier to leverage advantage and rise in positions,” said Prof Kitchin.
“Part of the problem with ERC applications is they are very large endeavours that take quite a lot of time to put together and have low rates of success, which puts people off who have very heavy loads and Ireland has very high staff to student ratios.”
“If we want success we have to identify who realistically stands a chance of getting one and to give them the time and space to put a competitive bid together,” said Prof Kitchin.
“ I think we do have some ‘premier league’ players but they are already significantly overcommitted.,” said Prof Kitchin. “ We either have to clone them, free them up, recruit others like them, or look to the generation slightly behind them.”